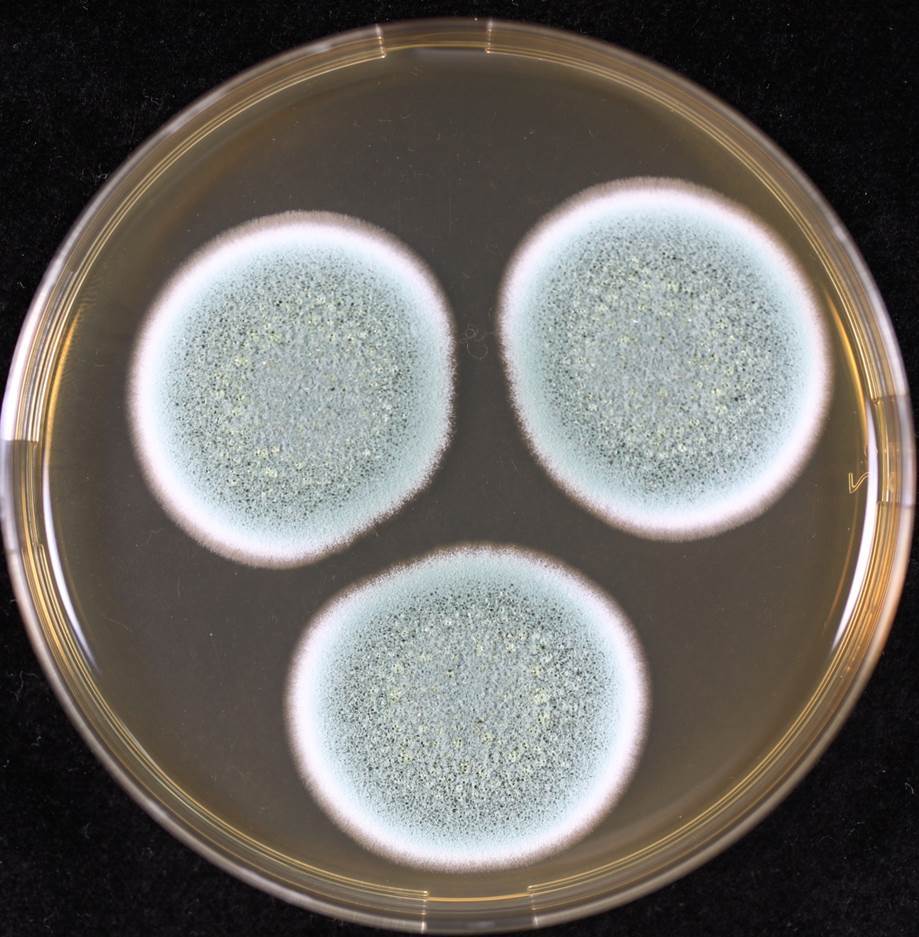
MEA-F (rev.).jpg

결로현상과 아파트 곰팡이
곰팡이이야기 16
아파트의 장롱과 드레스룸에 자란 곰팡이
겨울이 막 끝나가는 2월 어느 주말. 처(妻)가 장롱에 곰팡이가 피었다며 한걱정이다. 곰팡이를 당장 없애야 하니 도와 달란다.
처는 게으른 남편을 대신하여 웬만한 집안 일은 혼자 해치운다. 형광등 가는 것은 물론이고 이젠 문짝이 고장이 나도 직접 드릴로 구멍을 뚫고 나사를 박아가며 스스로 해결한다. 신혼 초에 남편에게 일을 시켜봤으나 공부한다는 핑계로 며칠, 몇주를 미루는 남편에게 더 이상 기대를 하지 않는다.
하지만 이번 건은 어쩔 수 없다. 장롱을 들어내야 되기 때문이다. 옷을 꺼내다가 장롱 안쪽의 모서리에서 푸른 색깔의 곰팡이를 발견하였다. 안쪽이 이렇다면 외벽과 접하는 뒤쪽은 필시 곰팡이가 많이 폈을 거란다.
 장롱 안쪽 모서리에 발생한 곰팡이
장롱 안쪽 모서리에 발생한 곰팡이승진시험 준비로 맘이 바빴지만 이거는 제 때에 협조하지 않으면 두고두고 원망을 들을 것이라는 동물적인 판단이 왔다. 바로 공사가 시작되었다. 먼저 장롱의 이불과 옷가지를 끌어내고 각자의 장을 연결한 나사를 해체하였다. 그리고는 장롱을 앞으로 들어 내었는데!

 내부벽체와 붙은 장롱의 뒷면
내부벽체와 붙은 장롱의 뒷면 이웃 장롱과 밀착된 장롱의 측면
이웃 장롱과 밀착된 장롱의 측면아뿔싸!
장롱 뒤편에 곰팡이가 말이 아니다. 곰팡이는 장롱을 지지하기 위하여 사용한 도색이 되지 않은 나무와 옆장롱과 인접한 측면에 많이 발생하였다. 곰팡이는 얼핏 푸른색으로 보여 푸른곰팡이, 클라도스포리움, 또는 아스페르길루스가 아닐까 했는데 자세히 보니 익숙한 곰팡이다. 흰색 균사, 녹색 포자, 노란색 자실체, 전형적인 좁쌀곰팡이다. 굳이 곰팡이를 순수분리하여 유전자 분석을 하지 않더라도 이것은 필시 좁쌀곰팡(Aspergillus section Aspergillus, 옛이름 Eurotium)이다.
이 곰팡이는 특별히 몸에 해로운 곰팡이는 아니다. 베란다 문을 활짝 열고 청소에 들어갔다. 먼저 물티슈로 닦아내고 세숫대야에 물을 담아 와서 물걸레로 몇 번이고 깨끗하게 닦아냈다. 굳이 락스를 이용하여 곰팡이를 죽일 필요성까지는 없을 것 같아 물걸레 청소까지만 했다. 그리고는 창문을 열어 놓은 채로 한 동안 말렸다.
안방이 이렇다면 비슷한 환경의 드레스룸은?
드레스룸의 옷들은 높은 습도로 눅눅함을 느낄 수 있었다. 옷을 꺼내어 확인하던 중에 왼쪽 팔에 유독 푸른색의 곰팡이가 많이 핀 등산복을 발견하였다. 이건 푸른곰팡이(Penicillium) 같은데 확인이 필요하겠다.
 드레스룸의 등산복. 우측 측면에 푸른곰팡이 많이 자랐다.
드레스룸의 등산복. 우측 측면에 푸른곰팡이 많이 자랐다.
등산복을 실험실로 가지고 왔다. 해부현미경으로 확대해보니 곰팡이실 균사와 푸른색의 포자가 명확하게 관찰되었다. 푸른곰팡이가 맞다.
 곰팡이가 핀 등산복 100X 확대 사진 (Dr. Aktaruzzaman 촬영)
곰팡이가 핀 등산복 100X 확대 사진 (Dr. Aktaruzzaman 촬영)좀 더 정확하게 종(種, species)까지 알 필요성이 있어 곰팡이를 순수 분리하여 배양하였다. 그리고 광학현미경으로 자세히 관찰하고 유전자 검사까지 실시하였다.
 등산복 곰팡이 Penicillium rubens MEA 배양 사진 (Dr. Aktaruzzaman 촬영)
등산복 곰팡이 Penicillium rubens MEA 배양 사진 (Dr. Aktaruzzaman 촬영) 등산복 곰팡이 Penicillium rubens 현미경 관찰 사진 (Dr. Aktaruzzaman 촬영)
등산복 곰팡이 Penicillium rubens 현미경 관찰 사진 (Dr. Aktaruzzaman 촬영)흥미롭게도 등산복에 자란 곰팡이는 알렉산더 플레밍의 실험실을 찾았던 그래서 항생제 페니실린을 발견하게 하였던 바로 그 곰팡이, 플레밍푸른곰팡이(Penicillium rubens)였다.
(* 이 곰팡이에 대하여는 여기서 길게 설명하지 않겠다. 몇 년 전에 이 이야기에 대하여 정리한 바가 있는데 다음의 곰팡이 이야기에서 확인 바란다.)
아파트의 장롱과 드레스룸에 왜 곰팡이가 피었을까?
필자의 집은 xx01호다. 01호가 의미하는 바는 두벽 중에 한벽은 외벽이라는 소리다. 우리동은 남향인데 각층 1호는 동쪽벽이 외벽이다. 그리고 안방과 드레스룸이 바로 이 외벽에 붙어 있고 곰팡이가 핀 등산복이 드레스룸 중에서 이 외벽에 붙어 걸려 있었다.
 필자의 아파트 단면도. 우측면이 외벽이고 곰팡이가 발생한 장롱과 드레스룸은 외벽에 붙어 있다.
필자의 아파트 단면도. 우측면이 외벽이고 곰팡이가 발생한 장롱과 드레스룸은 외벽에 붙어 있다.겨울 밤엔 안방 온도를 22도에 맞춰놓고 잔다. 이 경우에 안방 공기 중의 습도와 수분량은? 먼저 난방을 하기 전에 안방이 10도씨였고 상대습도가 50%였다고 해보자. 그러면 1 세제곱미터의 공기에 4.70g의 수분이 존재한다(아래 표 참조). 그런데 온도가 22도씨까지 올라가면 수분량은 같지만 상대습도는 24% [(4.70/19.40)*100]로 떨어진다.
 온도에 따른 공기의 수분함유량(g/m3). 가장 좌측 열이 온도이고 그 다음부터는 상대습도별 수분 함량. 10도씨, 습도 50%의 수분함량은 4.70g/m3(인터넷 자료)
온도에 따른 공기의 수분함유량(g/m3). 가장 좌측 열이 온도이고 그 다음부터는 상대습도별 수분 함량. 10도씨, 습도 50%의 수분함량은 4.70g/m3(인터넷 자료)나는 피부가 시원챦아 공기가 건조해지면 몸이 가려워진다. 따라서 가습기를 켜고 습도를 40%에 맞춘다. 사람은 일반적으로 상대습도 40-60%에서 상쾌함을 느낀다. 가습기가 수분을 공기중으로 방출하여 습도를 40%에 맞추게 되면 공기 1세제곱미터는 7.76g의 수분을 함유하게 된다. 22도씨에 습도 40%, 이 조건에서 나와 처는 숙면을 취한다(가습기는 이해를 위하여 인용하였고 실제 나는 젖은 수건을 걸어 놓고 잔다).
그렇다면 외벽과 장롱사이의 공간은? 겨울밤의 바깥기온은 영하이다. 이 찬기운이 아파트의 외벽을 타고 방 안쪽으로 전달된다. 철저하게 단열 시공되었다면야 이론적으로는 바깥 벽체는 영하이고 방 안쪽 벽체는 설정한 22도가 되어야 하지만 실제는 그러지 못하다. 바깥의 냉기가 내부로 전달되어 내부 벽체의 온도가 14도라고 가정해보자. 14도씨에서 최대 수분함량은 12.05g이므로 안방의 수분함량 7.76g은 상대습도 64% [(7.76/12.05)*100]에 해당된다.
공기 중에는 수분만 있는 것이 아니다. 다양한 곰팡이 포자도 함께 떠다닌다. 위치와 계절에 따라 다르지만 가장 흔한 곰팡이는 아스페르길루수, 푸른곰팡이, 클래도스포리움 등이다. 이들이 안방 공기 중을 떠다니는데 상대습도 40%에서는 이용할 수 있는 물이 없어 자랄 수 없다. 그런데 공기 중을 떠돌다가 장롱뒤쪽으로 가 봤더니 여기는 습도가 64%나 된다. 게다가 나무라는 좋은 먹을거리도 있다. 낮은 습도에서 자랄 수 있는 아스페르길루스 중의 좁쌀곰팡이(Aspergillus section Aspergillus, 예전 이름 Eurotium) 포자가 얼렁 뿌리를 내리고 균사를 내어 장롱에 자라기 시작한다.
한편 드레스룸은?
드레스룸은 안방의 북쪽에 위치하며 안방과는 문하나를 사이에 두고 있다. 안방의 공기와 온기가 드레스룸으로 전달되기는 하나 드레스룸은 안방에 비하여 춥다. 특히 내부 벽체의 온도가 외부 냉기의 영향으로 6도씨까지 떨어졌다고 하자. 그러면 공기 1m3 당 최대 수분함유량은 7.26g에 불과하다. 그런데 안방의 공기는 7.76g/m3의 수분을 가지고 있기 때문에 상대습도가 100%를 넘어 오히려 0.4g/m3은 이슬로 맺혀야 한다.
100%의 상대습도에서는 대부분의 곰팡이가 자랄 수 있고, 습도만 본다면 안방 공기 중에 있는 아스페르길루수, 푸른곰팡이, 클래도스포리움 포자 모두가 발아할 수 있다. 하지만 드레스룸은 춥다. 이 때에는 6도라는 낮은 온도에서만 자랄 수 있는 곰팡이만이 포자의 싹을 튀우고 균사를 내어 자랄 수 있다. 냉장고에서도 자랄 수 있는 플레밍푸른곰팡이(Pen. rubens)가 바로 그 곰팡이다.
"그리하여 지난 겨울 우리 부부가 안방의 22℃, 습도 40%에서 잠을 자고 사랑을 나누는 동안, 좁쌀곰팡이와 플레밍푸른곰팡이도 각각 장롱 뒤쪽의 14℃, 습도 64%와 드레스룸의 6℃, 습도 100%에서 포자 싹을 튀우고, 자라고, 사랑을 나누고, 자식을 만들었던 것이다. "
곰팡이는 어떤 조건에서 자라나?
어디에선가 곰팡이가 자라려면 3박자가 맞아야 한다. 첫째는 곰팡이가 있어야한다. 두 번째는 곰팡이가 자랄 수 있는 적정 환경이 필요하다. 그리고 마지막으로 곰팡이가 먹고 살 먹이가 필요하다.
첫 번째 조건인 곰팡이는 아파트 안에 항상 있다. 아파트 안에서만이 아니고 실외 공기 중에도 다양한 곰팡이 포자들이 늘 떠다닌다. 다만 아파트 내에 어떤 곰팡이들이 존재하는가는 아파트마다 그리고 계절마다 다르다.
두 번째 조건이 환경인데 온도와 습도가 핵심 요소이다. 일반적으로 곰팡이는 10℃ 정도에서 자라기 시작하여 25℃ 쯤에서 정점에 이르렀다가 35℃가 넘으면 자라지 못한다(온도 확인 및 참고문헌 필요). 우리가 음식을 냉장고에 보관하는 것은 냉장고의 온도가 보통 4℃인데 이 온도에서 곰팡이와 세균이 자라지 못하기 때문이다.
하지만 위에서 언급한 10-35℃는 일반적인 곰팡이 이야기이고 일부 곰팡이들은 4℃에서도 자라고, 또한 일부곰팡이는 37℃에서도 자란다. 따라서 전자는 냉장고의 음식을 상하게 할 수 있고 후자는 사람에게 병을 낼 수도 있다. 위의 드레스룸에서 자란 푸른곰팡이(Penicillium)는 4℃에서 자라는 대표적인 곰팡이다.
곰팡이가 자라기 위해서는 또한 적절한 수분이 필요하다. 우리가 곡식을 건조하거나 음식을 말리는 것은 곰팡이가 자랄 수 있는 범위 이하로 수분을 유지하고자 함이다. 곰팡이 중에 일부는 매우 낮은 습도에서도 자라는데 대표적인 곰팡이가 좁쌀곰팡이다. 상대습도가 그다지 높지 않은 64%의 장롱 뒤쪽에서 좁쌀곰팡이가 자란 것은 이 때문이다.
한편으로 장롱 뒤쪽에 좁쌀곰팡이가 자랐다는 것은 역설적으로 습도가 매우 높은 것을 아니라는 의미도 된다. 좁쌀곰팡이는 낮은 습도에서 자라며 습도가 매우 높으면 오히려 못자란다. 장롱 뒤쪽이 매우 습도가 높았다면 좁쌀곰팡이가 아닌 다른 곰팡이가 자랐을 것이다.
세 번째 곰팡이가 자라려면 당연히 먹이가 필요하다. 거실 전면의 많은 부분이 유리창이다. 겨울 철에 유리창에는 결로로 인하여 물이 줄줄 흐른다. 유리창은 곰팡이가 잘 자랄수 있는 온도와 습도이지만 곰팡이는 유리를 먹을 수가 없기에 유리에는 자라지 않는다. 대신에 창틀에 먼지와 실리콘에는 곰팡이가 자랄 수 있다.
곰팡이 마다 선호하는 먹이가 다르다.
내 장롱에 좁쌀곰팡이가 자랐다는 것은 내 장롱이 좁쌀곰팡이가 먹을 수 있는 먹이라는 뜻이다. 고급 원목에는 일반적으로 버섯류의 곰팡이가 자란다. 그런데 좁쌀곰팡이는 버섯류의 곰팡이가 아니다. 그렇다면 나의 장롱은 최소한 고급원목으로 만들어지지 않았다는 것이다. 아마도 톱밥을 압착하여 만든 합판? 장롱에 어떤 곰팡이가 피는 가에 따라 재료가 뭐고 얼마나 비싼 재료를 사용했는지도 판가름 할 수 있다. 우리집 장롱에 핀 곰팡이를 보아하니 이 장롱은 비싼자재를 쓰지는 않은 것 같다 ㅠㅠㅠ.
한가지만 더.
필자의 등산복에 자란 플레밍푸른곰팡이도 식성이 특이하다. 곰팡이도 사람처럼 단것을 좋아해서 홍시, 귤 등의 과일을 우선 좋아하고 다음으로 곡식을 탐내고 다음으로 나무 등의 거친 먹이를 먹는다. 그런데 내 등산복의 겉감은 나일론 84%에 폴리에스텔 14%다. 곰팡이가 참으로 먹기 어려운 것인데 이걸 먹어 치운다? 플레밍푸른곰팡이가 알렉산더 플레밍에게 항생제 페니실린의 대박을 안겨준 것처럼 필자에게 난분해 합성 고분자 쓰레기의 해법을 제시해줄려나? ^_^
플레밍푸픈곰팡이가 핀 등산복의 소재는 나일론 84%, 폴리에스텔 14%이다.
플레밍푸픈곰팡이가 핀 등산복의 소재는 나일론 84%, 폴리에스텔 14%이다.
내 아파트에 자란 곰팡이가 몸에 해롭지는 않은가?
곰팡이의 인체 안전성은 병원균 여부, 곰팡이독소 생성 여부, 알레르기 유발 여부의 세가지 측면을 고려한다.
일반적인 공기 중의 곰팡이는 건강한 사람에게는 인체에 병을 일으키지는 않는다. 좁쌀곰팡이, 플레밍푸른곰팡이도 병원균이라고 하기는 어렵다.
그리고 우리가 이 곰팡이가 핀 가구나 옷을 먹지는 않는다. 따라서 곰팡이독소 생성 여부는 우려 하지 않아도 된다. 좁쌀곰팡이는 해로운 곰팡이독소를 만들지 않고 플레밍푸른곰팡이는 일부 곰팡이독소를 만든다고는 하나 아주 독한 놈은 아니다.
다만 곰팡이는 조건만 맞으면 2-3일 안에도 수천만개, 수억개의 포자를 만들 수 있다. 그런데 이 곰팡이 포자라는 것이 미세먼지와 초미세먼지의 크기이다. 따라서 우리 몸에 쉽게 흡수되어 폐에 이를 수 있고 천식과 알레르기를 유발할 수 있다. 하지만 이것도 일반적으로 건강한 성인은 크게 우려하지 않아도 된다.
드레스룸에 발생한 플레밍푸른곰팡이의 포자는 3 um 크기로 초미세먼지 크기에 해당되고 사람에게 알레트기를 유발한다는 보고가 있기는 하다. 그리고 장롱에 발생한 좁쌀곰팡이는 푸른곰팡이보다는 큰 6 um 정도이다. 이 두 곰팡이가 천식, 알레르기 등 인체에 과민반응을 이르킬 수 있다고는 하는데..., 아마도 건강한 우리 부부에게는 별 문제을 일으키지는 않은 것으로 생각한다.
내 아파트에 자란 곰팡이 어떻게 처리할까?
겨울철 아파트 실내의 높은습도와 결로로 인한 곰팡이 발생의 해결책으로 가장 먼저 제시되는 것은 환기이다. 환기의 핵심은 곰팡이 발생에 필수 인자인 수분을 외부로 배출하는 것이다. 부엌, 욕실에서는 환기가 가장 좋은 방법이고 거실에서도 일부 적용 가능하다. 하지만 침실은 다르다. 수면을 위한 쾌적한 환경을 위해서는 적절한 수분이 필요하다. 따라서 침실은 환기로 수분을 제거하는 것이 온당치 않다.
나의 침실 장롱 뒤쪽의 경우에는 좁쌀곰팡이가 주로 발생하였다. 즉 이슬이 맺힐 정도의 높은 습도는 아니다. 이 경우는 좁은 공간에 정체되어 있는 공기를 흐르게한 해도 습도는 떨어질 수 있고 곰팡이 생장을 억제할 수 있다. 즉 장롱을 내부 벽체로부터 분리하여 조금만 앞으로 당겨주면 공기 순환이 생길 것이고 장롱뒤쪽과 접한 공기의 습도를 낮출 수 있을 것이다. 그래서 우리는 장롱을 벽면으로부터 10Cm 정도 앞으로 당겨 놓았다.
드레스룸의 경우에는 상대습도가 상당히 높다. 하지만 이 방은 겨울에 낮은 온도로 유지되지 때문에 절대 수분량 자체는 많지 않다. 따라서 '물먹는OO' 같은 제습제를 두는 것도 좋은 방법이겠다. 또한 이 방은 낮 시간의 적절한 환기가 곰팡이 방지에 도움이 된다. 그리고 좋은 날을 골리 옷을 한번씩 말려서 넣는 것도 좋은 방법이겠다.
맺음말
곰팡이가 발생하는 아파트의 가장 근본적인 대책은 벽면의 단열을 철저히 하는 것이다. 이는 아파트 시공사의 몫이다. 내 아파트의 장롱에 곰팡이가 핀 것도 기본적으로 외벽의 단열 시공의 불량에서 초래한다. 따라서 시공사가 해결해주는 것이 마땅하다.
해서 아파트 단열 문제에 대한 하자보수에 대하여 인터넷을 뒤졌더니 아뿔사 하자보수 기간이 2년이란다. 우리 아파트는 17년에 입주하여 올해가 3년째다. 하자보수 기간 내였으면 일 않코도 처에게 좋은 점수를 딸 수 있었을텐데, 집안 일엔 늘 별 도움이 되지 않는다.
할 수없이 일단 오는 겨울은 위에서 언급한 대로 버텨 볼려고 한다. 그래서 문제가 없으면 다행이고 혹시 문제가 계속되면 다음해에는 단열 시공을 내 돈으로라도 해야 되지 않을까? 시기를 놓친 데 대하여 배는 아프겠지만 대신 단열시공에 대하여 공부하면서 ‘곰팡이이야기’ 한편은 더 쓸 수 있지 않을까 ㅎㅎㅎ?
<2019. 05. 13. 곰박>